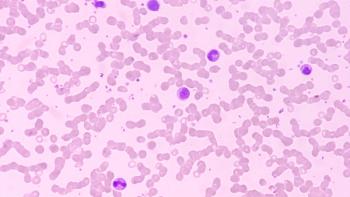
Image of bone marrow cells

Adagrasib Boosts Outcomes in KRAS G12C-Mutated Lung Cancer
Adagrasib outperformed docetaxel in patients with KRAS G12C-mutated non–small cell lung cancer, regardless of baseline brain metastases.
Adagrasib (Krazati) led to better outcomes compared with docetaxel for patients with previously treated KRAS G12C-mutated non–small cell lung cancer (NSCLC). The benefit was even observed in patients with baseline brain metastases according to findings from the phase 3 KRYSTAL-12 trial (NCT04685135), presented at the 2024 ESMO Annual Congress.1
Among patients with baseline brain metastases, the median intracranial time to progression was 18.6 months (95% CI; 9.6-not evaluable [NE]) in the adagrasib arm and NE (95% CI, 4.2-NE) in the docetaxel arm (HR, 0.60; 95% CI, 0.26-1.40 months). Additionally, the intracranial progression-free survival (PFS) hazard ratio for patients with brain metastases was 0.93 (95% CI, 0.50-1.73).
The study included 453 patients with KRAS G12C-mutated locally advanced/metastatic NSCLC who had been previously treated with platinum-based chemotherapy and anti-PD(L)1 therapy and who were randomized 2:1 to receive 600 mg BID of adagrasib orally or 75 mg/m2 every three weeks intravenously.
Patients with treated, neurologically stable brain metastases at baseline were eligible for participation, and 114 patients (25.2%) had baseline brain metastases (78 in the adagrasib arm, 36 in the docetaxel arm).
At a median follow-up of 7.2 months, median PFS was 4.4 months (95% CI, 3.1-5.8 months) in the adagrasib arm and 2.9 months (95% CI, 2.0-6.2 months) in the docetaxel arm among patients with brain metastases; 5.9 months (95% CI, 4.8-7.2) in the adagrasib arm and 3.9 months (95% CI, 2.4-5.6) in the docetaxel arm in patients without brain metastases.
Furthermore, the objective response rate (ORR) was higher in the adagrasib vs docetaxel arm among patients both with (26.9% vs 2.8%) and without (33.6% vs 11.2%) baseline brain metastases, as was the median duration of response (DOR) for patients with (7.4 vs 5.4 months) and without (8.3 vs 5.4 months) baseline brain metastases.
Treatment-related adverse events (TRAEs) were also reported to be comparable across treatment arms and irrespective of the presence of baseline brain metastases. Among patients with brain metastases, 94% of patients in the adagrasib arm and 86% of patients in the docetaxel arm experienced a TRAE, while among patients without brain metastases 94% and 87% of patients in the adagrasib and docetaxel arms, respectively, experienced a TRAE. There were 5 total treatment-related deaths, 4 among patients in the adagrasib arm without brain metastases and 1 in the docetaxel arm with brain metastases.
“Adagrasib demonstrated an improved intracranial efficacy over docetaxel in patients with treated, neurologically stable baseline brain metastases,” Professor Fabrice Barlesi, MD, PhD, thoracic oncologist, Paris Saclay University and chief executive officer of Gustave Roussy Institute, in France, said in a presentation of the findings. “Systemic overall response rate, duration of response and PFS were numerically greater with adagrasib compared to docetaxel, regardless of the presence of brain metastases, the safety profiles of adagrasib and docetaxel were comparable in patients with and without brain metastasis, and were consistent with all randomized patients. Overall, these results clearly reinforce adagrasib as an efficacious treatment option for patients including with baseline brain metastasis with previously treated KRAS G12C-mutated non–small cell lung cancer.”
Reference
Barlesi F, Yao W, Duruisseaux M, et al. Adagrasib (ADA) vs docetaxel (DOCE) in patients (pts) with KRASG12C-mutated advanced NSCLC and baseline brain metastases (BM): Results from KRYSTAL-12. Presented at: 2024 ESMO Congress; September 13-17, 2024; Barcelona, Spain. Abstract LBA57.
Newsletter
Knowledge is power. Don’t miss the most recent breakthroughs in cancer care.

















































































